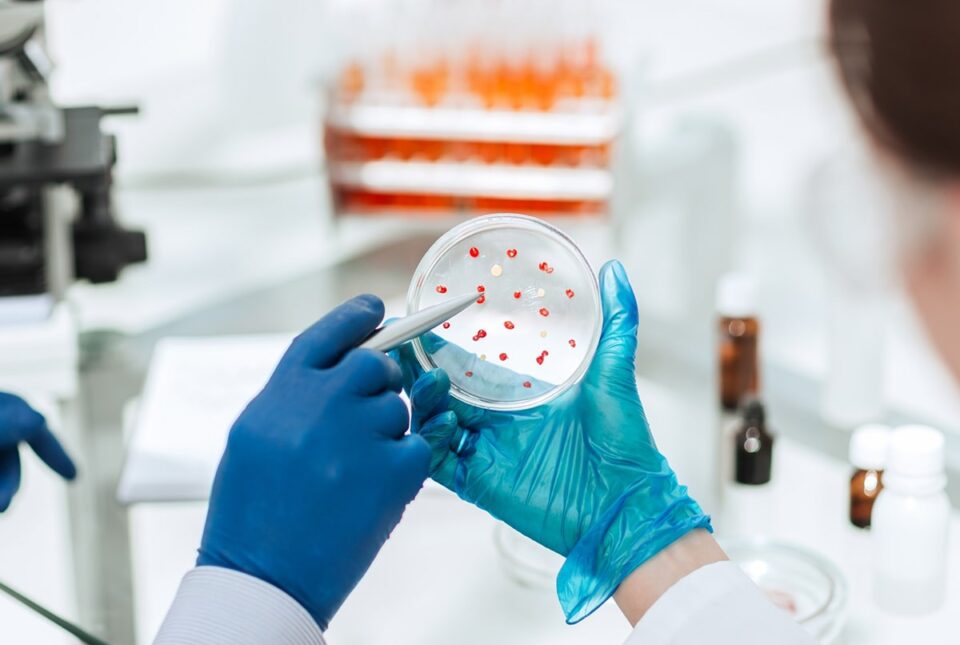
service-img-03

Transforming Sunshine into Sustainable
Lab service page can refer to a physical laboratory that performs diagnostic tests, a web page that lists lab services and allows booking, or a cloud-based service for setting up virtual labs. These pages typically provide information on available tests, pricing, and how to book appointments, and they can also be a place for customers to manage their accounts a view results These web pages list a wide range of medical tests, such as blood and urine analysis.
01
Sample Collection
Exploring the wonders of science through hands-on discovery.
02
Experimentation
Exploring the wonders of science through hands-on discovery.
03
Safety Disposal
Exploring the wonders of science through hands-on discovery.
These services focus on the operational aspects of running a lab, such as providing infrastructure, managing equipment, and handling regulatory compliance. A comprehensive list of all available tests, often with details on what they are for.
Central/Reference Laboratories
Large facilities offering a comprehensive range of highly specialised tests sites facilities.
Point of Care Testing Sites
Offices or urgent care clinics where simple tests are performed immediately for quick results.
Peripheral Laboratories
Often the patient's first point of contact offering basic screening and diagnostic tests.
Intermediate Laboratories
Regional hospitals, providing a broader range of tests and sometimes serving as referral labs.
Frequently asked Questions
Lab service FAQs cover a range of topics, including medical testing for diagnosis, product testing for quality and licensing, and technical services like for software testing. For medical tests, you typically get a doctor’s order, provide a sample at a clinic.
How do I know which financial service is right for me?
Every client’s situation is unique. During our consultation, we assess your goals, risk tolerance, income, and future plans to create a customized financial roadmap.
Do you work with individuals as well as businesses?
Every client’s situation is unique. During our consultation, we assess your goals, risk tolerance, income, and future plans to create a customized financial roadmap.
How often will we review my financial plan?
Every client’s situation is unique. During our consultation, we assess your goals, risk tolerance, income, and future plans to create a customized financial roadmap.
What makes your financial services different?
Every client’s situation is unique. During our consultation, we assess your goals, risk tolerance, income, and future plans to create a customized financial roadmap.